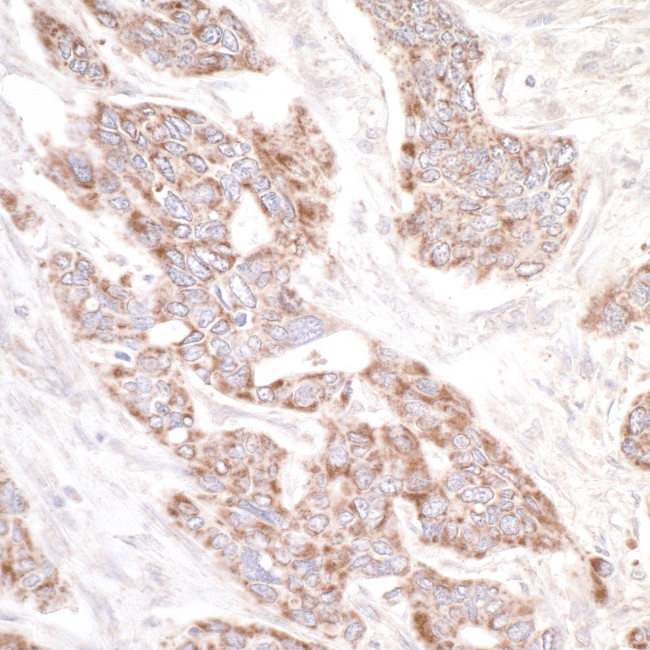
PDZ-GEF1 Antibody in Immunohistochemistry (Paraffin) (IHC (P))

Search
Bethyl Laboratories
PDZ-GEF1 Polyclonal Antibody
{{$productOrderCtrl.translations['antibody.pdp.commerceCard.promotion.promotions']}}
{{$productOrderCtrl.translations['antibody.pdp.commerceCard.promotion.viewpromo']}}
{{$productOrderCtrl.translations['antibody.pdp.commerceCard.promotion.promocode']}}: {{promo.promoCode}} {{promo.promoTitle}} {{promo.promoDescription}}. {{$productOrderCtrl.translations['antibody.pdp.commerceCard.promotion.learnmore']}}
产品信息
A301-966A
种属反应
宿主/亚型
分类
类型
抗原
偶联物
形式
浓度
规格
纯化类型
保存液
内含物
保存条件
运输条件
产品详细信息
The recommended shelf life for this product is 1 year from date of receipt.
Application Note: For IHC, epitope retrieval with citrate buffer pH 6.0 or Tris-EDTA pH 9.0 is recommended for FFPE tissue sections.
Based on 100% sequence identity, this antibody is predicted to react with Dog
靶标信息
Functions as a guanine nucleotide exchange factor (GEF), which activates Rap and Ras family of small GTPases by exchanging bound GDP for free GTP in a cAMP-dependent manner. Serves as a link between cell surface receptors and Rap/Ras GTPases in intracellular signaling cascades. Acts also as an effector for Rap1 by direct association with Rap1-GTP thereby leading to the amplification of Rap1-mediated signaling. Shows weak activity on HRAS. It is controversial whether RAPGEF2 binds cAMP and cGMP (PubMed:23800469, PubMed:10801446) or not (PubMed:10608844, PubMed:10548487, PubMed:11359771). Its binding to ligand-activated beta-1 adrenergic receptor ADRB1 leads to the Ras activation through the G(s)-alpha signaling pathway. Involved in the cAMP- induced Ras and Erk1/2 signaling pathway that leads to sustained inhibition of long term melanogenesis by reducing dendrite extension and melanin synthesis. Provides also inhibitory signals for cell proliferation of melanoma cells and promotes their apoptosis in a cAMP-independent nanner. Regulates cAMP-induced neuritogenesis by mediating the Rap1/B-Raf/ERK signaling through a pathway that is independent on both PKA and RAPGEF3/RAPGEF4. Involved in neuron migration and in the formation of the major forebrain fiber connections forming the corpus callosum, the anterior commissure and the hippocampal commissure during brain development. Involved in neuronal growth factor (NGF)-induced sustained activation of Rap1 at late endosomes and in brain- derived neurotrophic factor (BDNF)-induced axon outgrowth of hippocampal neurons. Plays a role in the regulation of embryonic blood vessel formation and in the establishment of basal junction integrity and endothelial barrier function. May be involved in the regulation of the vascular endothelial growth factor receptor KDR and cadherin CDH5 expression at allantois endothelial cell-cell junctions.
仅用于科研。不用于诊断过程。未经明确授权不得转售。
篇参考文献 (0)
生物信息学
蛋白别名: CNrasGEF; Cyclic nucleotide ras GEF; KIAA0313; Neural RAP guanine nucleotide exchange protein; nRap GEP; PDZ domain containing guanine nucleotide exchange factor (GEF) 1; PDZ domain-containing guanine nucleotide exchange factor 1; PDZ-GEF1; RA(Ras/Rap1A-associating)-GEF; RA-GEF-1; Rap guanine nucleotide exchange factor (GEF) 2; Rap guanine nucleotide exchange factor 2; Ras/Rap1-associating GEF-1; unnamed protein product
基因别名: CNrasGEF; KIAA0313; nRap GEP; NRAPGEP; PDZ-GEF1; PDZGEF1; RA-GEF; RA-GEF-1; RAGEF; Rap-GEP; RAPGEF2
UniProt ID: (Human) Q9Y4G8
Entrez Gene ID: (Human) 9693